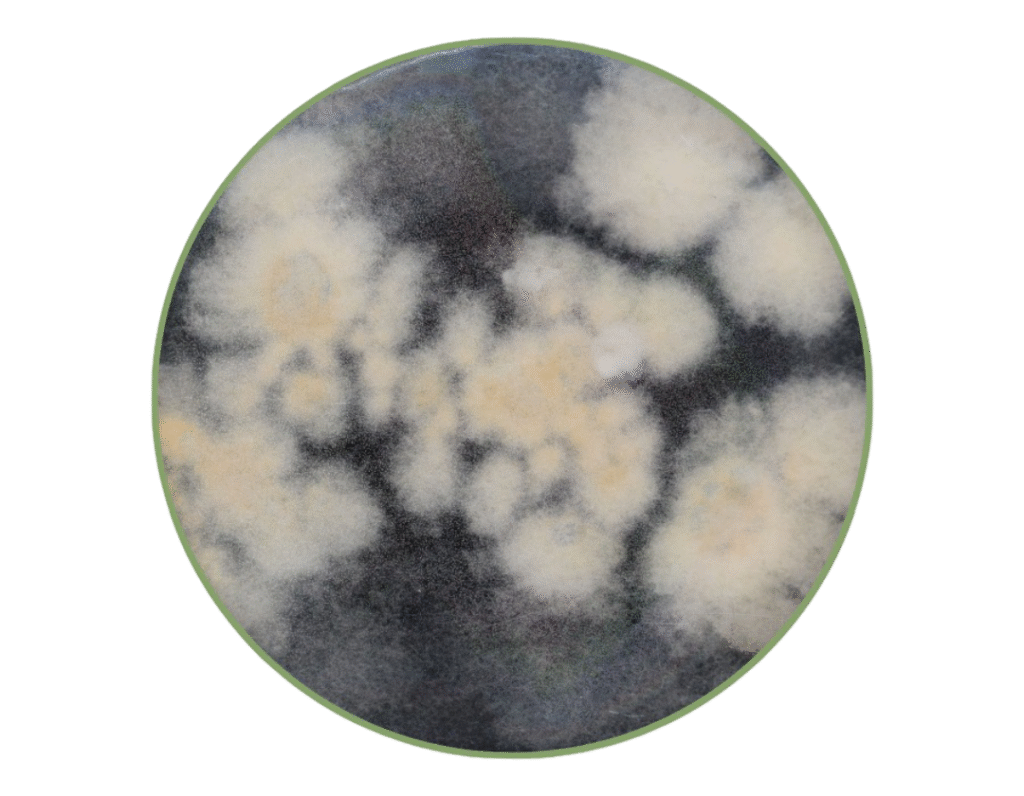
3 (1)
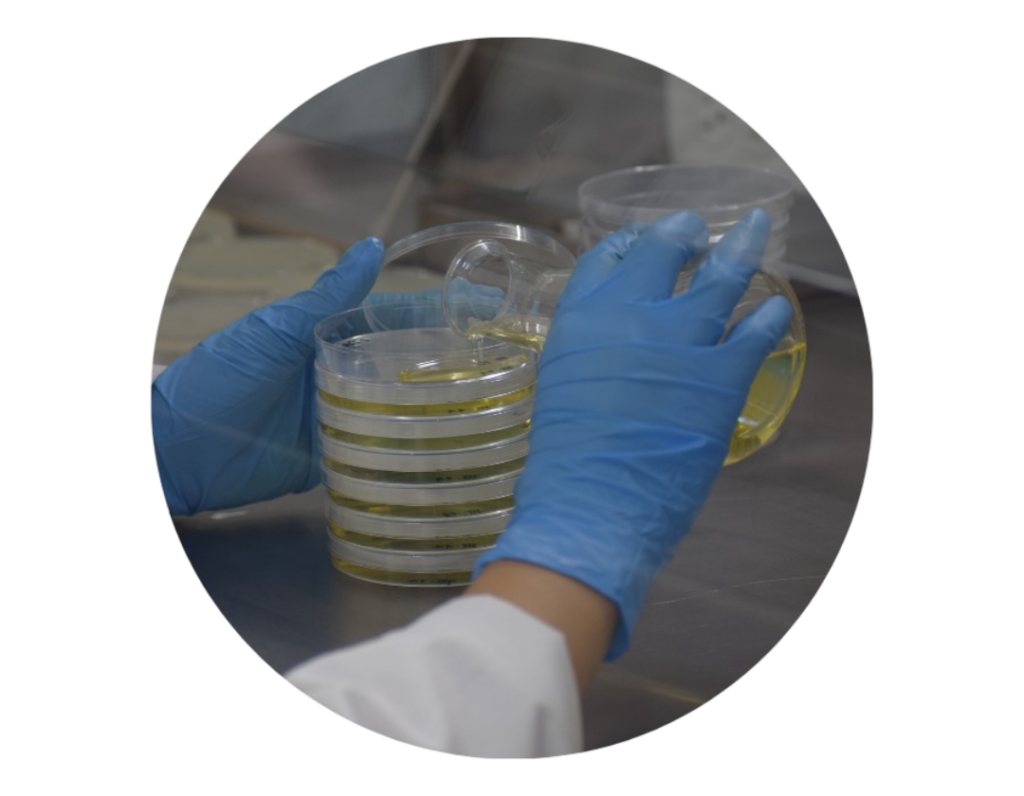
10
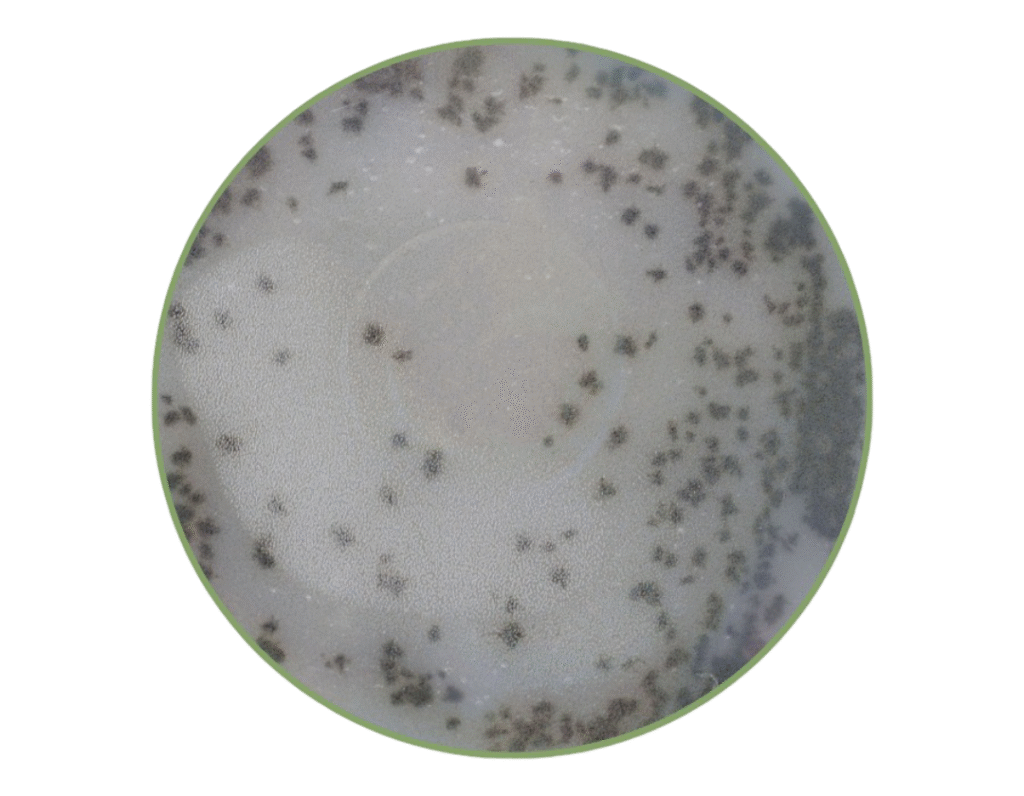
2
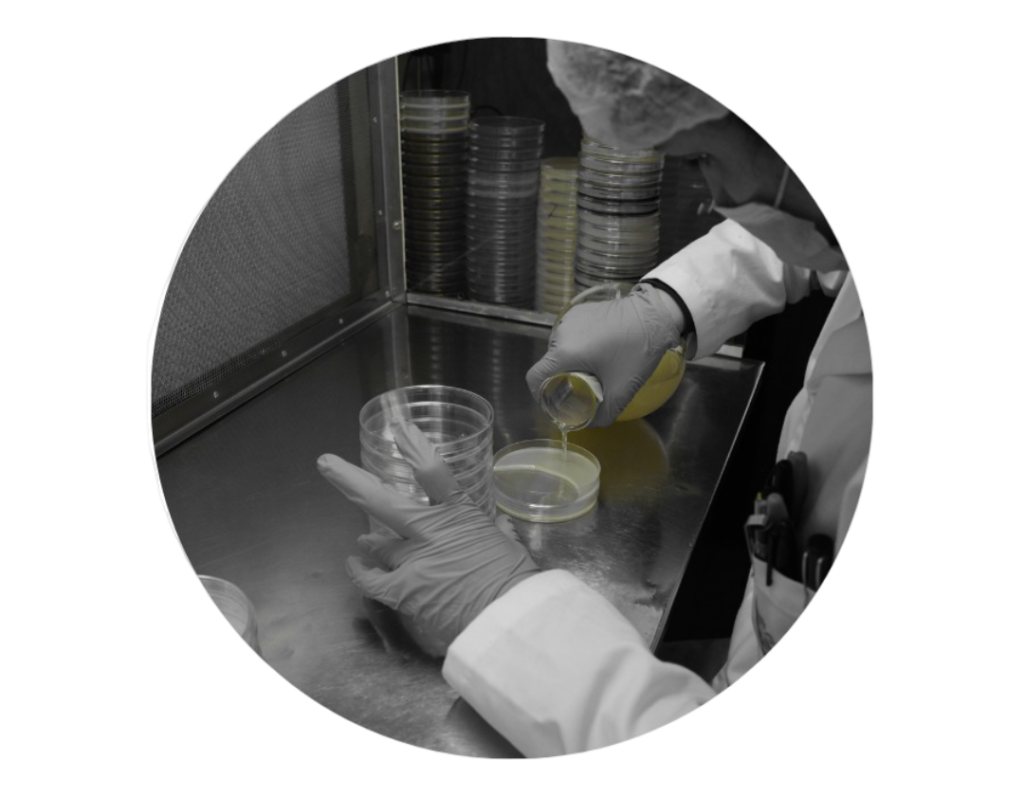
3 (1)

Registrados ante el ICA bajo la norma NTC: ISO-17025: No. LB 0000352022
Vigente hasta: 2032.06.09

Invertir en diagnóstico fitopatológico preventivo es asegurar la salud de tus cultivos y el éxito de tu producción, ahora y en el futuro.

Un patógeno no espera. En condiciones ideales, puede destruir un cultivo antes de que el productor siquiera note los síntomas.

En Agrodiagnóstico brindamos servicios de manejo fitosanitaria en pre-siembra y post-siembra (ISO 17025). Practicas fundamentales en Global Good Agricultural Practices (G.A.P.)
✓ Identificar enemigos ocultos: Entienda las causas de las enfermedades que afectan sus cultivos, ya sean hongos, pseudohongos, bacterias o nemátodos.
✓ Proteger su inversión: Evite pérdidas económicas significativas causadas por plagas y enfermedades.
✓ Cultivar un futuro sostenible: Implemente prácticas agrícolas responsables y reduzca el uso de agroquímicos.
✓ Garantizar la seguridad alimentaria: Asegure la calidad e inocuidad de sus productos agrícolas para el bienestar de sus consumidores.
AGRODIAGNÓSTICO SAS
administracion@agrodiagnostico.com.co
REGISTRO ICA
Registrados ante el ICA bajo la norma NTC-17025